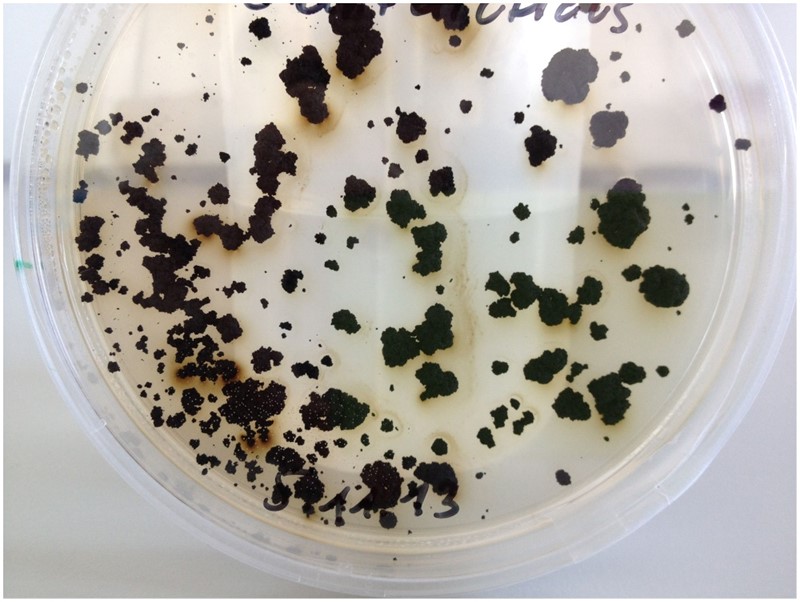

Ima li gljiva na Mjesecu?
Ima li života u svemiru – i kako ga naći? Naći ćemo ga ako znamo koje molekule, biomarkere, treba tražiti. Odgovor na to pitanje daje istraživanje gljiva u svemiru, u putanji oko Zemlje.
Kada veliki meteorit, asteroid ili – najpreciznije rečeno – impaktor udari u Zemlju, na mjestu udara nastaje, zna se, krater. No kamo je nestao sav onaj materijal iz te velike rupe, a i sam impaktor? Od impaktora ne ostane ništa, a nema ništa ni od velikog dijela stijena na mjestu udara; od silne vrućine stijene se ne samo rastale nego i rasplinu. Stup usijane pare (ali ne vodene!) potom sune visoko u zrak gdje se s njom događa isto što i s onom vodenom: rasplinute stijene dijelom se kondenziraju u staklene kuglice, sferule, a dijelom u nekoliko centimetara velike kapi koje potom, kao tektiti, padaju na zemlju. (Jao onome kome padnu na glavu!)
No nije sve u i oko kratera vruće. Kinetička energija impaktora pretvara se, istina, u toplinu, ali ne sva. Nešto od nje preostane da razmrvi mnoge kubične kilometre okolnih stijena te da velik dio materijala u hladnom stanju izbaci iz kratera. Ti komadi, ovisno o veličini i brzini, lete desetke kilometara od kratera, no neki imaju toliku brzinu da mogu savladati silu teže matičnog planeta – i pobjeći u svemir.
Namjerno kažem „matičnog planeta“, a na „Zemlje“ jer takvo je djelovanje impaktora sveopća svemirska pojava. Već je pronađeno mnogo meteorita koji su nam došli s Marsa i Mjeseca. Među njima je najpoznatiji ALH84001, Marsov meteorit što je 1984. godine pronađen na Antarktici, jer su u njemu pronađene strukture nalik bakterijama. I tako je, zahvaljujući otkriću toga i drugih njemu sličnih meteorita, oživljena jedna stara teorija, teorija litopanspermije iz 19. stoljeća: svemir je pun sitnih svemirskih tjelešaca što su ih meteorski udari lansirali u svemir – razlika je jedino u tome što su u 19. stoljeću mislili kako je njihov postanak uzrokovan erupcijom vulkana. Postoji li na planetu s kojeg potječe meteorit život, meteorit će ga prenijeti na drugi planet, na planet na koji padne. I tako se život prenosti kroz svemir, tko zna već koliko milijarda godina...
Teorija je, kažem, stara, ali su problemi novi. Ako je do nas došao komadić Marsa, kako ćemo u njemu pronaći tragove života? Ili, na drugi način: uzmemo li stijenu s Mjeseca, možemo li u njoj pronaći tragove života sa Zemlje, jer je razumno pretpostaviti da i Zemlja obasipa Mjesec svojim stijenama kao što Mjesec obasipa nju.
Odgovor na to pitanje potražila je skupina talijanskih, francuskih, njemačkih i južnoafričkih znanstvenika te svoje rezultate objelodanila ove godine u znanstvenom radu „Investigation of fungal biomolecules after Low Earth Orbit exposure: a testbed for the next Moon missions“, objavljenom u časopisu Environmental Microbiology. Oni su, ukratko, pomiješali osušene kolonije jednostanične gljive Cryomyces antarcticus sa smjesom minerala koja sastavom odgovara Mjesečevom tlu (regolitu) te ih 16 mjeseci izložili nedaćama svemirskog vakuuma i zračenja pričvrstivši ih za Međunarodnu svemirsku stanicu.

Odabir baš te vrste nije slučajan: već samo ime gljivice govori da ona raste u ekstremnim uvjetima hladnoće (Cryomyces) i to baš na Antarktici (antarcticus). No, to nije sve. Riječ je o crnoj gljivi, a crnoća joj potječe od melaninskih pigmenata, pigmenata koji štite gljive, no i druga živa bića, od zračenja. Melanin se usto lako otkriva po karakterističnom spektru u ultraljubičastom području zračenja.
Prvi znak uspjeha istraživanja bio je nalaz da se spektar melanina nije promijenio, što znači da bi melanin bio dobar biomarker za pronalaženje tragova života na Mjesecu no i na drugim tijelima Sunčevog sustava. U uzorku izloženom svemiru otkriveno je još pet kemijskih spojeva koji potječu od crne jednostanične gljive, poput mliječne i palmitinske kiseline. No oni ne bi mogli biti dobri biomarkeri, jer mogu nastati i neživim, abiogenim procesima. Njihov nalaz u Mjesečevoj ili Marsovoj stijeni ne bi dakle bio dokaz da život na njima postoji ili da je nekoć postojao.

Tako što se ne bi moglo reći za DNA. Stoga su autori spomentog rada, služeći se standarnim testom za analizu gena (polymerase chain reaction, PCR), tražili u uzorku dva gena iz jednostančne glive. Prvi gen, LSU, dug je 939, a drugi, β-aktin, 330 parova baza. (Uspješnost umnažanja gena metodom PCR ovisi o njegovoj dužini, duži gen – bolja analiza, a oštećenja gena smanjuju osjetljivost metode.) Tako je i bilo: bolji je nalaz dao za uzorak s dna umjetnog regolita (koji je bio bolje zaštićen od zračnja) od onoga što se nalazio na vrhu.
Sve u svemu, u uzorcima stijena s drugih planeta ima smisla tražiti melanin, a još bolje DNA. Jesu li te molekule nastale na Marsu ili su pak nošene meteoritima došle sa Zemlje – s tim pitanjem neka si taru glavu oni koji ih pronađu.

Nenad Raos, rođen 1951. u Zagrebu, je kemičar, doktor prirodnih znanosti i znanstveni savjetnik, sada u mirovini. Još od studentskih dana bavi se popularizacijom znanosti pišući za časopise Prirodu (kojoj je sedam godina bio glavni urednik), Čovjek i svemir, ABC tehnike, Smib, Modru lastu, i, naravno, BUG online. Autor je 13 znanstveno-popularnih knjiga od kojih je jednu, „The Cookbook of Life – New Theories on the Origin of Life“ napisao na engleskom jeziku. Sada je glavni urednik mrežnih staranica Panopticum. Nagrađen je Državnom godišnjom nagradom za promidžbu i popularizaciju znanosti 2003. godine.